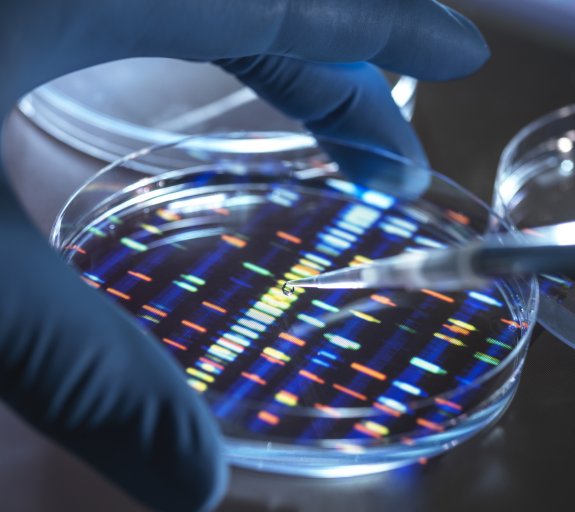

DNAがどのように医学の世界を変え、今日の投資機会をけん引しているか
キーポイント
-
DNAの発見およびヒトゲノム(ヒトの全遺伝子情報)計画が、バイオテクノロジーと医療におけるイノベーションの素地を作った
-
テクノロジーの進化により遺伝子配列解読が高速化されたことで、バイオテクノロジー企業はより早く薬を開発できるようになった
-
当社では、遺伝子医療分野に魅力的な長期の投資機会があると見ている
科学界は2023年4月に2つの主要な記念日を迎えました。それぞれが医学の道のりを変え、今日まで続く科学の革新において重要な要素となっています。
生物学者ジェームズ・ワトソンと自然科学者フランシス・クリックがDNAの二重らせん構造の発見を発表してから70年になります。
4月はまた、人の遺伝子情報全体をマップ化したヒトゲノム計画の完成20周年でもあります。これは、数十年にわたる科学革新と発見を結集した国際的偉業です。
バイオテクノロジーセクターの革新的な性質が、長年にわたり投資家の注目を惹きつけてきたことは驚くまでもありません。そして時にボラティリティの高いセクターとなりえる反面、過去20年間で500%超という目覚ましいリターンを達成しています。1
遺伝学の新時代
デオキシリボ核酸(DNA)は4つの塩基の繰り返しからなる高分子で、どのように生物の発生のための遺伝子指令を運んでいるのかを理解することは、多くの医療の進歩、特に遺伝医学で非常に重要です。これらの塩基の順序が私たち個々の遺伝子情報を形成し、この固有のコードを測定する科学が遺伝子配列決定として知られています。
これらの進歩に功績したとされる先駆者は数多く、一部の人々は業績がノーベル賞で称えられています。ワトソン、クリック、モーリス・ウィルキンスが1962年にDNA構造解明でノーベル賞を受賞し、ポール・バーグ、ウォルター・ギルバート、フレデリック・サンガーは遺伝子配列決定の発展における功績で1980年に受賞しています。
最近では、エマニュエル・シャルパンティエとジェニファー・ダウドナがゲノム編集技術「CRISPR/Cas9(クリスパー・キャスナイン)」の開発で2020年にノーベル化学賞を、そしてスバンテ・ペーボが人類の進化に対する画期的な研究で昨年ノーベル賞を受賞したばかりで、遺伝学に関する私たちの理解をさらに深めています。
もちろん、ロザリンド・フランクリン(DNA構造解明に貢献したが、37歳で死亡)を含み、この分野に多大な貢献を行いながら正式な認識がないままの人々が多くいます。
そして科学者は今日、過去の業績からアイデアを得て、またその上に築き上げる作業を続けています。簡単な科学文献の検索で、遺伝学に関して2022年だけで32万5,000件を超える科学論文が発表されたことがわかります。これはこの分野で行われている絶大な量の研究を示しており、今日のバイオテクノロジーにおける多くの進歩や投資機会の基盤となっています。2
ヒトゲノム計画の完成により、科学者が疾患の根底にある遺伝的原因を調査および理解することができる、医学イノベーションの新時代の幕が開けました。多くの疾患が複数の遺伝子や環境刺激に起因する複雑なものである一方、単一の遺伝子変異によって引き起こされる個々の疾患は5,000から8,000に上ると考えられています。3
多種のがんが今や特定の遺伝子変異によって引き起こされることが分かっており、がんは現在多くの病院で、体内のがんの部位よりも遺伝子要因によって診断され、治療されています。米国では現在、根底にあるがんの遺伝子異常を標的として疾患を治療するがんの治療が180以上承認されています。4
現在では百万以上の疾患が遺伝学に関連していると特定され、研究が進んでいます。5 発達障害に関する英国を拠点とした10年がかりの膨大な研究が最近、説明のつかない疾患をもつ子供のある13,500例以上の家族の遺伝子コードを分析し、5,500例に診断を下すことができました。このプロセス中に60の新たな疾患が特定されました。6
イノベーションはさらに加速
遺伝子配列決定にかかる時間と費用は、解読技術の急速な改良により過去20年間で大幅に削減されました。最初のヒトゲノムの配列決定には、13年と27億ドル(約3,600億円)の費用がかかりました。今日では最近の技術により、ゲノム全体の相当量の配列決定が数秒で行われ、わずか200ドルの費用でできます。これは多数の新たな発見につながる躍進的な発展です。
DNAの構成要素と、それらがどのように私たちのゲノムを形成するのかについての理解もまた、疾患の発見から診断と治療法の開発までのスピードを急速に加速させました。たとえば、脊椎性筋萎縮症(SMA)は1890年代に医師により初めて発見されましたが、この進行性の筋肉変性疾患の原因となる変異遺伝子の特定にはおよそ100年がかかりました。
その後、SMAの根底にある遺伝的原因の最初の治療薬が承認されるまでに20年かかりました。それがバイオテクノロジー企業のバイオジェン( Biogen)およびアイオニス( Ionis)による Spinraza です。同疾患の治療薬として他に2種、Zolgensma(Novartis/AveXis 製)および Evrysdi(Roche/PTC Therapeutics 製)が承認されるのに4年しかかかりませんでした。これらの治療薬は、この稀でしばしば致命的な疾患をもって生まれた子供たちの展望を劇的に変えました。7
もうひとつの画期的な例が、新型コロナウイルス・ワクチンの開発です。米バイオテクノロジー企業のモデルナ(Moderna)と米国立衛生研究所が最初にウイルスの遺伝子配列を受け取ってから mRNA ベースのワクチンの人体テストを開始するのに63日しかかかりませんでした。8 そして1年も経たないうちに、ワクチンは緊急承認を受けました。ビオンテック(BioNTech)、ファイザー(Pfizer)、モデルナ による mRNA 型の新型コロナウイルス・ワクチンは、市場に出た最初の年だけで770万人以上が死を免れたとする最近のデータがあります。9
長期的な投資機会の可能性
医学における遺伝学の利用は急速なペースで進歩しており、バイオテクノロジー投資家にとって有望な新たな機会を生んでいます。研究、配列決定、分析、応用に必要な成分など、バリューチェーンのすべての主要要素について、広範な産業に今後の機会があります。
どのような新技術にもあるように、乗り越えるべき障害がまだあり、開発から商業的成功に移行するには時間がかかります。しかし強力な長期的ファンダメンタルズに支えられ、人口動態とライフスタイルの構造的変化に後押しされたバイオテクノロジーは、強い追い風を受けていると当社は見ています。
遺伝子に関する理解を、研究、発見、開発の中核に置いている医薬品・バイオテクノロジー企業は、現在と将来の双方で患者と医療従事者にとって巨大な価値を創造しており、魅力的な長期の投資機会となっています。
企業への参照は例示のみを目的としており、投資推奨と見なされるものではありません。
(オリジナル記事は4月25日に公開されました。こちらをご覧ください。)
- IDIwMjPlubQ05pyIMjTml6Xnj77lnKjjgILlh7rmiYDvvJpOYXNkYXEgQmlvdGVjaG5vbG9neSBJbmRleOOAgumBjuWOu+OBruODkeODleOCqeODvOODnuODs+OCueOBr+WwhuadpeOBruODquOCv+ODvOODs+OBruebruWuieOBqOOBl+OBpuaNieOBiOOCi+OBueOBjeOBp+OBr+OBguOCiuOBvuOBm+OCkw==
- KChnZW5ldGljKSBPUiAoZ2VuZSkpIE9SIChnZW5vbWljcykgLSBTZWFyY2ggUmVzdWx0cyAtIFB1Yk1lZCAobmloLmdvdik=
- Um9kd2VsbCwgQy4sIEF5bcOpLCBTLiAoZWRzLikgKDIwMTQpLiAyMDE0IFJlcG9ydCBvbiB0aGUgU3RhdGUgb2YgdGhlIEFydCBvZiBSYXJlIERpc2Vhc2UgQWN0aXZpdGllcyBpbiBFdXJvcGUgUGFydCBJSTogS2V5IERldmVsb3BtZW50cyBpbiB0aGUgRmllbGQgb2YgUmFyZSBEaXNlYXNlcyBpbiBFdXJvcGUgaW4gMjAxMy4gUHAuMeKAkzkwLiA=
- U291cmNlOiBOYXRpb25hbCBDYW5jZXIgSW5zdGl0dXRl
- U291cmNlOiBEaXNHZU5FVCAtIGEgZGF0YWJhc2Ugb2YgZ2VuZS1kaXNlYXNlIGFzc29jaWF0aW9ucw==
- VGhvdXNhbmRzIHJlY2VpdmUgZGlhZ25vc2lzIGFmdGVyIDYwIG5ldyBkaXNlYXNlcyBmb3VuZCwgQkJDIE5ld3MsIEFwcmlsIDIwMjM=
- IOacrOiomOS6i+OBp+iogOWPiuOBleOCjOOBpuOBhOOCi+S8gealreOBr+S+i+ekuuOBruOBv+OCkuebrueahOOBqOOBl+OAgeaKleizh+aOqOWlqOOBp+OBr+OBguOCiuOBvuOBm+OCk+OAgiA=
- IOODoeODg+OCu+ODs+OCuOODo+ODvFJOQeOBr+OCv+ODs+ODkeOCr+izquWQiOaIkOOBq+OBiuOBkeOCi+S4u+imgeOBqumBuuS8neWtkOOBruODoeODg+OCu+ODs+OCuOODo+ODvOOBp+OBmeOAgg==
- QWlyZmluaXR5LCBXYXRzb24gYW5kIEJhcm5zbGV5IGV0IGFsLiAyMDIy
ご留意事項
本ページは情報提供のみを目的としており、特定の有価証券やアクサ・インベストメント・マネージャーズ・グループ(アクサIM)またはその関連会社による投資、商品またはサービスを購入または売却するオファーを構成するものではなく、またこれらは勧誘、投資、法的または税務アドバイスとして考慮すべきではありません。本資料で説明された戦略は、管轄区域または特定のタイプの投資家によってはご利用できない可能性があります。本資料で提示された意見、推計および予測は掲載時の主観的なものであり、予告なしに変更される可能性があります。予測が現実になるという保証はありません。本資料に記載されている情報に依拠するか否かについては、読者の独自の判断に委ねられています。本資料には投資判断に必要な十分な情報は含まれていません。
投資リスクおよび費用について
当社が提供する戦略は、主に有価証券への投資を行いますが、当該有価証券の価格の下落により、投資元本を割り込むおそれがあります。また、外貨建資産に投資する場合には、為替の変動によっては投資元本を割り込むおそれがあります。したがって、お客様の投資元本は保証されているものではなく、運用の結果生じた利益および損失はすべてお客様に帰属します。
また、当社の投資運用業務に係る報酬額およびその他費用は、お客様の運用資産の額や運用戦略(方針)等によって異なりますので、その合計額を表示することはできません。また、運用資産において行う有価証券等の取引に伴う売買手数料等はお客様の負担となります。
アクサ・インベストメント・マネージャーズ株式会社
金融商品取引業者 登録番号: 関東財務局長(金商) 第16号
加入協会: 一般社団法人日本投資顧問業協会、一般社団法人投資信託協会、一般社団法人第二種金融商品取引業協会、日本証券業協会
お問い合わせ先:TOKYOMARKETING@axa-im.com